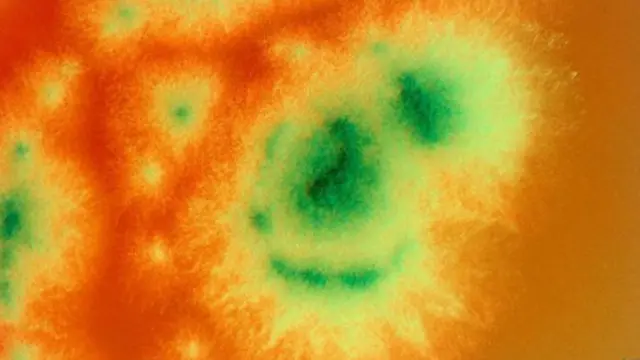
(图片来源:SPL)

探索奶酪里面奇妙的微型生态

图像来源, Getty
奶酪曾经是延长鲜奶存放时间的主要方法,而如今,它已然成了美食达人的最爱。从带有金色斑点的斯蒂尔顿奶酪到扭动着活蛆的萨尔蒂尼蛆虫奶酪,很多奶酪甚至成了勇敢者的试金石。有些奶酪制作者甚至用自己腋窝和脚趾上的菌类制作奶酪。
不过,并不是只有行家才懂得欣赏这些微生物搭建的城堡。每一个奶酪都是一座由细菌和真菌搭建的“房子”,每一栋“房子”也都会因为里面居民的品味不同,而拥有自己独特的建筑结构。
要制作这种细菌性建筑,起初要在鲜奶中混入乳杆菌或链球菌,使之变酸。然后加入酶,再剪去鲜奶蛋白的尾巴。没有了尾巴,蛋白质就会以固体形式从鲜奶中分离出来,同时还会带走球状脂肪。取出这些凝块并进行挤压后,就制成了一块等待陈化的奶酪。
在陈化过程中,其他微生物将会陆续发挥自己的独特作用。例如,洛克福奶酪是一种点缀着青色裂纹的奶酪。这种“房子”的建造者是娄地青霉菌,这是一种在法国的山洞里生长的天然真菌,真正的洛克福奶酪都是在那里陈化的,但世界各地的奶酪制造商都可以自行将其加入到新鲜奶酪中,从而达到类似的效果。
图像来源, SPL
娄地青霉菌是一种敏感的微生物,它虽然喜欢空气,但如果氧气含量过高仍会导致其死亡。所以,制造商需要用金属针在奶酪上穿刺出一些具有防护作用的小孔,让这种真菌可以安全生长。一旦它们在里面安家,就会生成酶,将奶酪脂肪分解成脂肪酸,带来圆润的口感。同时还将生成带有独特香味的甲基酮。这种真菌产生的毒素会对老鼠的心、肺、肝、肾造成损伤。但在奶酪里,这种物质就会发生分解,使毒性降低。

图像来源, Getty
带有白色外皮的胶黏奶酪是彻头彻尾的“真菌性建筑”,卡芒贝尔奶酪便是其中之一。沙门柏干酪青霉菌是里面的主要居民,它们在表面安营扎寨,并生成能在奶酪核心部位产生连锁反应的酶。通过吸收乳酸盐,它们便可让奶酪的表面酸度高于内部,令原本分散在奶酪结构中的磷酸钙离子转移到表面。这种酸度变化和离子移动导致奶酪的内部液化。而在表面,更多的蛋白质酶解后产生了氨,扩散到奶酪中,为卡芒贝尔奶酪赋予了独一无二的香气。除了这种复杂的往复运动外,还有一整套其他的化学反应。有一篇论文解释了奶酪是如何成熟的,其中一句话特别有趣:“甲硫基丙醛本身那种煮土豆的味道并不好闻,但与其他挥发物混合后,却会帮助卡芒贝尔奶酪和切达奶酪散发出独特的芳香。”
伊泊斯奶酪和林堡奶酪等洗浸奶酪需要在陈化过程中多次浸泡在盐水中,里面居住的主要是亚麻短杆菌。这种微生物为可以生成酪酸和异戊酸等分子,从而让奶酪发出汗脚般的恶臭。事实上,人的臭脚味的确来自这种微生物,因为它会附着在皮肤表面,并在那里发挥自己的魔力。雌性冈比亚按蚊会被林堡奶酪的恶臭吸引。由亚麻短杆菌陈化而成的奶酪都带有一股恶臭,但对奶酪爱好者来说却是难得的美味。

图像来源, Getty
制作切达奶酪的要领是成熟过程必须温和,不能过于粗野。这些奶酪往往只使用在一开始就加入的乳酸菌发酵剂来进行陈化,不会添加太多额外的菌类。但它们还是通过一系列的嗅觉和味觉分子的混合物产生了独特的味道。如果你闻一闻切达奶酪的味道,或许就会发现它的气味非常复杂。这种气味很开胃,但也带有一丝甜味和咸味,而且非常圆润。事实上,奶酪就像红酒,专业人士可以使用很多词汇来描述它的味道。在2001年发表的这篇论文中,研究人员品尝了240片切达奶酪,并设计了27个词汇来描述它的味道,包括:猫尿味、牛膻味、果仁味、肉汤味和水果味。

图像来源, Thinkstock
过去几个世纪的各种实验造就了如今令人垂涎欲滴的各种奶酪。科学家仍在努力探究是哪些微生物造就了这些美食——研究人员通常会从奶酪中的分子列表和菌类样本开始,然后找出后者是如何产生前者的。但我们对细节了解得越深入,就越是会被奶酪深深吸引。当你下一次切开这个由微生物建造的城堡时,无论是经过充分陈化的卡芒贝尔奶酪还是大块的切达干酪,都应该想想这些小东西所做的贡献。
请访问 <link type="page"><caption> BBC Future</caption><url href="http://www.bbc.com/future" platform="highweb"/></link> 阅读 <link type="page"><caption> 英文原文</caption><url href="http://www.bbc.com/future/story/20141114-the-strange-world-inside-cheese" platform="highweb"/></link>。
(责编:友义)